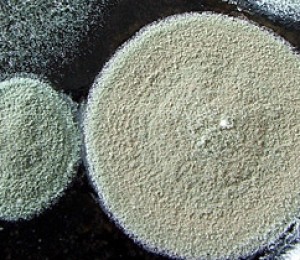

Concursul se desfasoara online, pe site-ul Prettyuglyfurniture, marele premiu fiind de 5.000 de euro. Pe langa el sunt acordate o multime de alte premii.
Pentru a participa, trebuie sa gasesti cea mai urata piesa de mobilier, sa-i faci o poza si sa o trimiti la adresa de pe site. Nu este foarte complicat si poate deveni chiar amuzant daca te duci prin casele prietenilor tai sau pe la vecini in cautarea obiectului perfect pentru concurs. Poti participa la competitie numai in perioada 8.02.2008 – 20.04.08. In cazul in care te vei numara printre castigatori, poti sa te duci linistita cu banii in cel mai apropiat magazin BoConcept si sa-ti iei de acolo mobila si accesorii, valorificand astfel banii castigati.
Ca sa-ti faci o idee despre cum poate sa arate obiectul pe care il pozezi, poti sa intri pe linkul de mai sus si ai acolo o multime de exemple cu cele mai urate canapele si dulapuri din editiile precedente ale concursului.
De ce ai participa la acest concurs? In primul rand este amuzant si in al doilea rand ti se ofera sansa sa-ti achizitionezi un set nou de mobila de la cel mai celebru retailer de mobila din Danemarca. BoConcept are un stil propriu si un design minimalist, punand accentul pe flexibilitatea pieselor de mobilier, facand astfel mult mai accesibila amenajarea spatiilor limitate din mediul urban.








































 Reamenajarea casei cu electrocasnice de ultima generatie
Reamenajarea casei cu electrocasnice de ultima generatie
Adio mucegai!
Adio mucegai!














































